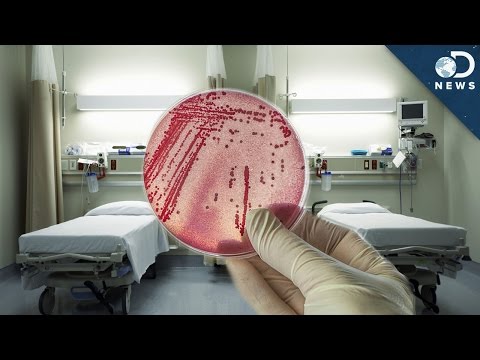
Why Superbugs Thrive In Hospitals

About giant bugs results of 8,712
 13:15
13:15 00:54
00:54 10:01
10:01 09:22
09:22 17:42
17:42 03:32
03:32 04:01
04:01 04:53
04:53 04:47
04:47 04:47
04:47![Owl City - 99 Red Balloons [Cover] Lyrics](https://img.youtube.com/vi/8bGyN5CobAs/hqdefault.jpg) 01:04
01:04 01:00
01:00 05:16
05:16 10:09
10:09 10:28
10:28 07:48
07:48 01:10
01:10 07:07
07:07 01:13
01:13 01:20
01:20 11:55
11:55 14:48
14:48 13:16
13:16 03:55
03:55 01:48
01:48 11:19
11:19 06:51
06:51 04:33
04:33 17:43
17:43 04:58
04:58 03:43
03:43 10:37
10:37 05:33
05:33 07:07
07:07 06:36
06:36 04:09
04:09 07:49
07:49 01:14
01:14 04:18
04:18 06:47
06:47 01:40
01:40 03:10
03:10 02:02
02:02 20:59
20:59 06:10
06:10 14:35
14:35 10:01
10:01 17:42
17:42 07:48
07:48 01:20
01:20 14:48
14:48 13:16
13:16 04:58
04:58 10:01
10:01 17:42
17:42 07:48
07:48 01:20
01:20 14:48
14:48 13:16
13:16 04:58
04:58